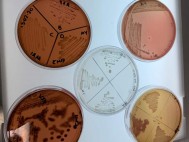

|
Estatal.-
Van 5,199 muertes por COVID-19 en Veracruz; se acumulan 38,353 casos confirmados |
| En la entidad han sido estudiados 73 mil 109 casos, de éstos, 25 mil 046 resultaron negativos.
2020-11-15 21:54:55 |
 |

|
Estatal.-
Advierte Jefa de Programa de Gobierno que Cuitláhuac no dejará gubernatura de Veracruz; éste no es el último informe |
| La funcionaria estatal acudió este domingo al Congreso del Estado, acompañada del secretario de Gobierno, Eric Cisneros Burgos, quien solo alborotó el avis... 2020-11-15 21:53:52 |
 |

|
Estatal.-
Pobladores de Las Choapas denuncian que PC les mandó solo 50 despensas para más de 500 familias afectadas por inundaciones |
| Y es que, a decir de los pobladores damnificados de aquel municipio del sur del Estado, la SPC solo mandó 50 despensas que entregaban sobre una lista rigur... 2020-11-15 21:52:11 |
 |

|
Nacional.-
López-Gatell pide no descartar vacuna de Pfizer |
| Hasta el momento nuestro país cuenta con un millón seis mil 522 casos confirmados por coronavirus
2020-11-15 21:50:07 |
 |

|
Nacional.-
Marcha feminista termina en actos vandálicos en Cancún |
| Colectivos feministas protestaron por la inseguridad, la violencia contra la mujer y los feminicidios registrados en Quintana Roo
2020-11-15 21:17:55 |
 |

|
Nacional.-
Grupo armado secuestra a fotoperiodista en Sinaloa |
| Periodistas de Mazatlán y Culiacán se manifestaron para exigir la aparición con vida del fotoperiodista Carlos Zataraín
2020-11-15 21:15:07 |
 |

|
Mundo.-
Trump pretende dejar a Nueva York sin vacuna contra Covid-19 |
| El mandatario expresó su sentir en un tweet publicado el 14 de noviembre
2020-11-15 21:13:34 |
 |

|
Mundo.-
Farmacéutico alemán afirma que con vacuna contra Covid-19 "la vida normal" está por llegar |
| Investigador alemán sostiene que la vacuna de Pfizer llegará pronto
2020-11-15 21:12:01 |
 |

|
Mundo.-
Bebé es diagnosticada con rara enfermedad derivada del Covid-19 |
| Una bebé fue diagnosticada con un síndrome ocasionado por el virus
2020-11-15 21:10:42 |
 |

|
Nacional.-
SCJN concluye que se el viola derecho a la salud cuando no se suministran antirretrovirales |
| La decisión de la SCJN sucede a la resolución de 2 amparos de pacientes con VIH en contra de un hospital en Querétaro que interrumpió su tratamiento.
2020-11-15 20:15:02 |
 |

|
Mundo.-
Temporal deja sin luz a 400 mil personas en Asunción, Paraguay |
| Los cortes de electricidad afectaron varios hospitales donde el personal médico y paramédico asistió a sus pacientes a oscuras. 2020-11-15 20:13:32 |
 |

|
Nacional.-
Secretario de Salud de Hidalgo se contagia de Covid-19 |
| El funcionario anunció que continuará con sus actividades en aislamiento
2020-11-15 20:12:00 |
 |

|
Nacional.-
Personal del Invea acude a suspender restaurante Fisher´s en CdMx y los corren a golpes |
| En la videograbación se aprecia cómo los verificadores son resguardados por elementos policiacos ante las agresiones por parte de los trabajadores del resta... 2020-11-15 20:05:28 |
 |

|
Nacional.-
Coronavirus: 1 de cada 5 pacientes desarrolla una enfermedad mental |
| El estudio de la Universidad de Oxford también encontró riesgos significativamente más altos de padecer demencia o deterioro cerebral.
2020-11-15 19:26:59 |
 |

|
Mundo.-
Incendia hospital por fumar mientras usaba una máscara de oxígeno |
| El hombre identificado como Lee Williams causó la evacuación del hospital y provocó daños estimados en más de un millón 261 mil pesos
2020-11-15 19:25:44 |
 |

|
Nacional.-
Coronavirus en México al 15 de noviembre: Más de un millón de casos y 98 mil 542 muertes |
| Hugo López-Gatell restó importancia al hecho de haberse superado el millón de casos confirmados y lamentó que medios sigan con esos conteos
2020-11-15 19:24:22 |
 |

|
Nacional.-
Contaminación agrava emergencia sanitaria, dice CEDH de Jalisco |
| En el pronunciamiento la defensoría señala el riesgo de perturbación de la respuesta del sistema inmunológico por la polución en el aire, aumentando aún más... 2020-11-15 19:23:09 |
 |

|
Mundo.-
Supera EU los 11 millones de contagios de Covid-19 |
| Texas y California han reportado cada uno más de un millón de casos. Florida ha registrado 875 mil 96 casos e Illinois 573 mil 616 casos, con lo que superó ... 2020-11-15 19:21:59 |
 |

|
Tecnología.-
Despega cohete de SpaceX con 4 astronautas hacia la estación espacial |
| Este es el segundo vuelo tripulado de SpaceX, una empresa privada fundada por Elon Musk, que transportará a astronautas de la NASA después de que Estados Un... 2020-11-15 19:21:05 |
 |

|
Deportes.-
Javier Mascherano dice adiós al futbol |
| El mediocampista argentino anunció su retiro del balompié profesional este domingo tras el duelo de Estudiantes de La Plata ante Argentinos Juniors
2020-11-15 19:19:31 |
 |

|
Nacional.-
Absurda, versión de que Ebrard operó el voto a favor de Trump en Texas: SRE |
| Daniel Millán, director de Comunicación en la dependencia, rechazó la información que se le atribuye a Ben Rhodes, exconsejero adjunto de Seguridad Nacional... 2020-11-15 19:18:30 |
 |

|
Nacional.-
INE garantiza realización de elección 2021 pese a recorte |
| Lorenzo Córdova, consejero presidente, detalló que en los días por venir el organismo analizará escenarios y rutas de trabajo para poder llevar a cabo la co... 2020-11-15 19:17:18 |
 |

|
Nacional.-
Expertos reportan 74 infectados por lepra en México |
| La enfermedad ha vuelto a tener un repunte tras un descenso notorio en 2019
2020-11-15 19:11:07 |
 |

|
Nacional.-
En México un menor de edad es asesinado de forma violenta diariamente, alertó Causa En Común |
| En lo que va del año al menos 320 menores han sido asesinados
2020-11-15 19:10:08 |
 |

|
Nacional.-
Iota se intensifica a huracán categoría 2; así afectará a México |
| El Servicio Meteorológico Nacional informó que "Iota" se ha intensificado a huracán categoría 2 y se mantiene vigilancia en México
2020-11-15 19:09:11 |
 |

|
Nacional.-
AMLO: Se perjudicó a más pobres, pero teníamos que tomar una decisión sobre lluvias en Tabasco |
| El Presidente dijo que en este año llovió más que en el 2007, sin embargo, Villahermosa no se inundó como en ese entonces.
2020-11-15 19:06:16 |
 |

|
Nacional.-
192 de 207 legisladores de Morena piden aliarse a cualquier partido para garantizar mayoría en 2021 |
| Los diputados también invitaron a los partidos Verde Ecologista de Mexico (PVEM), del Trabajo (PT) y Encuentro Social (PES) a mantener la alianza en 2021, c... 2020-11-15 19:04:57 |
 |

|
Mundo.-
Golpean a manifestante durante marcha por Donald Trump en Washington DC |
| Un hombre acabó en el piso luego de recibir un fuerte golpe por la espalda durante la marcha que se llevó a cabo en Washington DC
2020-11-15 17:16:31 |
 |

|
Mundo.-
Boris Johnson, en aislamiento tras contacto con infectado de Covid-19 |
| Johnson, que estuvo gravemente enfermo del Covid-19 en primavera, se encuentra "bien" y no tiene "ningún síntoma" de la enfermedad, precisó la misma fuente,... 2020-11-15 17:14:32 |
 |

|
Nacional.-
Repliegan a normalistas de Ayotzinapa que 'tomaron' caseta |
| Los estudiantes arribaron alrededor de las 11 de la mañana a la zona, según informaron, con la finalidad de obtener recursos para algunas acciones que reali... 2020-11-15 17:13:41 |
 |

|
Mundo.-
Erdogan rechaza reunificación de Chipre |
| "Hay dos pueblos y dos Estados separados en Chipre. Hacen falta conversaciones para una solución sobre la base de dos Estados separados" afirmó Erdogan dura... 2020-11-15 17:12:37 |
 |

|
Mundo.-
Brasileños eligen alcaldes y concejales en todo el país |
| Las principales disputas se dan en Sao Paulo el mayor colegio electoral del país y Río de Janeiro. 2020-11-15 17:11:44 |
 |

|
Nacional.-
Alerta Cofepris por venta ilegal de vacuna contra influenza en redes sociales |
| El sector salud destaca que comprar dicho producto en redes sociales representa un riesgo para la salud, ya que no se garantiza la seguridad, calidad y efic... 2020-11-15 17:09:40 |
 |

|
Sociedad.-
Pese a millón de casos covid en México, siguen fiestas, 15 años
|
| Durante el fin de semana se atendieron 142 reportes de eventos en Torreón, Coahuila; en Durango se clausuraron 11 expendios de venta de bebidas alcohólicas
... 2020-11-15 17:08:41 |
 |

|
Mundo.-
Venezuela acuerda con Rusia compra de 10 millones de vacunas Sputnik V, afirma Maduro |
| El gobierno venezolano ha confirmado desde marzo, cuando la pandemia llegó al país, 96 mil 933 contagios y 848 muertes
2020-11-15 17:06:26 |
 |

|
Nacional.-
Decomisan pruebas Covid sin permisos de salud |
| El aseguramiento de 11 mil 600 piezas tuvo lugar en la aduana de Ciudad Juárez, Chihuahua
2020-11-15 17:05:29 |
 |

|
Nacional.-
Vinculan a proceso a socio de inmobiliaria beneficiado en Estafa Maestra |
| Luis Antonio Valenciano Zapata fue vinculado a proceso por los delitos de delincuencia organizada
2020-11-15 17:04:25 |
 |

|
Nacional.-
ALERTA: Periodista de Noroeste de Mazatlán está desaparecido. Lo buscan Ejército, Marina y policía |
| Los hechos ocurrieron alrededor de las 23:00 horas del sábado, cuando, según versiones, un grupo armado a bordo de un vehículo llegó a un domicilio de la Co... 2020-11-15 17:00:45 |
 |

|
Nacional.-
Empresas de Salinas Pliego abren en plena restricción y retan a la autoridad en Chihuahua: Corral |
| Las empresas de Grupo Salinas, entre las que se encuentra esta televisora, se niegan a colaborar, en medio de esta pandemia, escribió el mandatario estata... 2020-11-15 16:59:03 |
 |

|
Mundo.-
OMS reporta nuevo récord de casos diarios de Covid-19 en el mundo |
| Las cifras superan en más de 15 mil contagios diarios el récord previo, del viernes, y en más de 45 mil el anterior que se había contabilizado el 7 de novie... 2020-11-15 15:16:45 |
 |

|
Mundo.-
Sondeos dan el triunfo a Maia Sandu en elecciones de Moldavia |
| Las proyecciones Sandu 55 por ciento, Dodon 45 por ciento se basan sólo en entrevistas a boca de urna dentro de Moldavia, sin considerar el voto de la amp... 2020-11-15 15:15:56 |
 |

|
Mundo.-
Más de 500 detenidos por protestas en Bielorrusia |
| El grupo Viasna reportó que las detenciones se realizaron en la capital Minsk y en otras ciudades como Vitebsk y Gomel.
2020-11-15 15:14:51 |
 |

|
Nacional.-
Covid-19 puede dañar páncreas y provocar diabetes: IPN |
| Isabel Salazar Sánchez instó a adquirir hábitos de vida saludables y realizarse periódicamente un estudio que determine su índice de glucosa en la sangre
... 2020-11-15 15:12:52 |
 |

|
Deportes.-
Arrestan a Kevin Porter de los Cavaliers |
| El joven basquetbolista de Cleveland fue detenido por posesión de armas de fuego y posteriormente liberado tras pagar una multa
2020-11-15 15:11:34 |
 |

|
Mundo.-
Covid-19 ya estaba en Italia mucho antes de primer caso en China, asegura estudio |
| El análisis realizado por el Instituto Nacional del Cáncer de la ciudad de Milán, reveló que el Covid-19 desde septiembre mucho antes de que se reportara el... 2020-11-15 15:10:01 |
 |

|
Nacional.-
Carpas voladoras, tropa sin líder ni eco. El show de FRENA en el Zócalo llegó a su fin |
| Son varios episodios del campamento FRENA que se quedan en la memoria de los capitalinos. Desde las casas vacías y mojadas en la primera noche del plantón, ... 2020-11-15 15:07:45 |
 |

|
Nacional.-
Niños de 7 y 13 son asesinados en CdMx. Una de 10 es herida; también un adulto. Y el detenido tiene 14 |
| Policías de la Ciudad de México acudieron esta mañana a un domicilio de la Alcaldía Venustiano Carranza, donde dos menores fueron asesinados y una más resul... 2020-11-15 15:06:10 |
 |

|
Nacional.-
El INE detalla: eran 5,530 muertos los que votaron en la consulta para enjuiciar a expresidentes |
| El 1 de octubre, el pleno de la Suprema Corte de Justicia de la Nación (SCJN) dio seis votos a favor de la iniciativa del Presidente Andrés Manuel López Obr... 2020-11-15 15:03:58 |
 |

|
Nacional.-
Rechaza Encinas fracaso de aprehensión de militares por los 43 |
| En un mensaje en su cuenta de Twitter, esta mañana el funcionario señaló: Con relación a la nota publicada hoy en primera plana de @LaJornada respecto al c... 2020-11-15 13:29:03 |
 |

|
Nacional.-
Recupera GN 15 tractocamiones robados en Jalisco |
| El operativo inició con el reporte de robo de un tráiler acoplado a un semirremolque tipo jaula, por lo que autoridades municipales y estatales activaron su... 2020-11-15 13:27:39 |
 |

|
Nacional.-
Detienen en Guanajuato a presuntos asesinos del periodista Israel Vázquez |
| A través de Twitter, la dependencia afirmó que esclareció el homicidio y que con el apoyo de la Guardia Nacional, la Secretaría de la Defensa Nacional y la ... 2020-11-15 13:25:21 |
 |

|
Mundo.-
'Iota' se convierte en huracán en su avance a Centroamérica |
| La tormenta 'Iota' se fortalece a huracán de categoría 1, mientras avanza lentamente por el Caribe hacia Centroamérica
2020-11-15 13:19:02 |
 |

|
Sociedad.-
Vaticina Iglesia Navidad triste si se relajan medidas ante Covid |
| Urgen autoridades eclesiásticas a la población a hacer viral la alerta de contagio y a seguir medidas sanitarias; llama a dar de regalo la vida y la esper... 2020-11-15 13:17:40 |
 |

|
Policiaca.-
Dan prisión preventiva a padrastro por violación |
| Domingo Luis amenazó a su hijastra para no decir nada; la agresión tuvo lugar en 2017; el victimario fue detenido el pasado 5 de noviembre
2020-11-15 13:16:20 |
 |

|
Mundo.-
BioNTech, socio de Pfizer, prevé fin de pandemia hasta finales de 2021 |
| El director del laboratorio alemán BioNTech, que desarrolla una vacuna anticovid en colaboración con la estadunidense Pfizer, espera un retorno a la normali... 2020-11-15 13:14:53 |
 |

|
Mundo.-
Manuel Merino no dura ni una semana como Presidente de Perú: renuncia en medio de protestas |
| El legislador del partido Acción Popular (AP) Manuel Merino juró el martes como Presidente de Perú ante el pleno del Congreso y ratificó que respetaría la f... 2020-11-15 13:10:03 |
 |

|
Nacional.-
Proceso: Morena tenía cuarto de guerra dentro de oficinas del Ayuntamiento de Hermosillo |
| Fue el robo en un domicilio en el fraccionamiento Santa Bárbara de Hermosillo, Sonora, lo que reveló el cuarto de guerra del Movimiento Regeneración Nacio... 2020-11-15 13:07:57 |
 |

|
Nacional.-
PAN exigirá a FGR una investigación contra los responsables de las miles de muertes por la COVID |
| Además, el PAN anunció que realizarán una Jornada Nacional de luto como un acto de solidaridad con sus familias y un nuevo llamado de atención ante el mal ... 2020-11-15 13:06:03 |
 |

|
Nacional.-
Sandoval, Duarte, Tornado y El Bronco: cómo caballos y vacas asociaron a los gobernadores |
| Roberto Sandoval fue Gobernador de Nayarit entre 2011 y 2017. Fue en su último año donde medios nacionales señalaron su vínculo con Coahuila y César Duarte.... 2020-11-15 13:04:26 |
 |

|
Policiaca.-
En dos ataques ejecutan a siete personas en Salamanca |
| Alrededor de las 21 horas del sábado, de manera simultánea se perpetraron dos ataques, uno en la calle Puerto Seguro, en donde hubo seis víctimas y el otro ... 2020-11-15 11:14:53 |
 |

|
Mundo.-
Israel y EU se unieron para eliminar al número dos de Al Qaeda |
| Estados Unidos proporcionó inteligencia a los israelíes sobre dónde podrían encontrar a Al-Masri y el alias que usaba, mientras que los agentes israelíes ll... 2020-11-15 11:14:05 |
 |

|
Mundo.-
Nuevas protestas en Europa contra restricciones anti Covid |
| En las últimas 24 horas, se registraron nueve mil 246 nuevas muertes y casi 608 mil contagios.
2020-11-15 11:12:59 |
 |

|
Nacional.-
Ambientalistas en riesgo de prisión por oponerse a proyecto hotelero |
| Lo que pretenden es confundir al asegurar que su propiedad está fuera del área natural protegida, cuando realmente buscan construir a un costado del cuerpo... 2020-11-15 11:11:32 |
 |

|
Deportes.-
Hamilton iguala récord de títulos mundiales de Schumacher |
| El piloto británico de la escudería Mercedes consiguió su séptimo campeonato en la máxima categoría y alcanzó la marca del legendario expiloto alemán
2020-11-15 11:09:17 |
 |
|
Nacional.-
Bacterias ayudan a recuperar suelos dañados por hidrocarburo: IPN |
| La bacteria Sphingobium yanoikuyae mostró su potencial en procesos de degradación como: Tolueno, naftaleno, fenantreno y xileno; Microbacterium petrolearium... 2020-11-15 11:08:10 |
 |

|
Mundo.-
Pese a Covid-19 Cuba reabre el Aeropuerto Internacional de la Habana |
| Con la reapertura el gobierno cubano espera el retorno de miles de ciudadanos varados en otros países tras el inicio de la pandemia
2020-11-15 11:06:25 |
 |

|
Mundo.-
Matan a 2 jóvenes durante protestas contra el presidente de Perú |
| El presidente dijo que las protestas en las calles son por el desempleo
2020-11-15 09:54:28 |
 |

|
Mundo.-
Deja 'Vamco' al menos 42 muertos en Filipinas |
| Entre los muertos había al menos 12 aldeanos, cuyos cadáveres fueron desenterrados de entre aludes de lodo y rocas en las provincias norteñas de Cagayán y N... 2020-11-15 09:48:34 |
 |

|
Mundo.-
Incendio en hospital rumano deja 10 muertos y 7 heridos |
| Las llamas arrasaron la unidad de cuidados intensivos destinada a enfermos de coronavirus en el hospital público de la ciudad norteña de Piatra Neamt, dijo ... 2020-11-15 09:47:31 |
 |

|
Mundo.-
Argentina rebasa los 1.3 millones de contagios de Covid-19 |
| Con ocho mil 468 nuevos contagios contabilizados este sábado, el total de positivos ascendió a un millón 304 mil 846 casos, de los cuales un millón 119 mil ... 2020-11-15 09:46:32 |
 |

|
Sociedad.-
Subió 63% consumo de alcohol durante el confinamiento |
| Según un estudio de Kantar, en el mes de abril, que fue cuando comenzaron a darse las medidas de aislamiento social en el país, el gasto en botanas y bebida... 2020-11-15 09:45:30 |
 |

|
Nacional.-
Reafirma Ricardo Monreal que Fonden no es necesario |
| EL Fonden operaba para emergencias, pero era más el pasivo que el activo que contenía ese fondo, ahora el presidente de la república, con recursos del er... 2020-11-15 09:44:35 |
 |

|
Nacional.-
EPOC, novena causa de muerte en México |
| En el mundo, se estima que 64 millones de personas tienen esta enfermedad, que está conformada por dos padecimientos: el enfisema pulmonar y la bronquitis c... 2020-11-15 09:43:14 |
 |

|
Mundo.-
Forman en Asia el mayor bloque comercial del mundo |
| La Asociación Económica Integral Regional, o RCEP por sus siglas en inglés, se firmó de forma virtual en un aparte de la cumbre anual de la Asociación de Na... 2020-11-15 09:41:59 |
 |

|
Nacional.-
Ligan desaparición de 8 mil niños a cooptación forzada |
| Gran parte de los menores reclutados son utilizados como halcones o para cosechar mariguana y rayar amapola
2020-11-15 09:30:47 |
 |

|
Mundo.-
Violencia, riñas y detenidos en protestas a favor de Trump |
| La jornada de protestas en Washington y otras ciudades de EU a favor del presidente Donald Trump degenera en enfrentamientos, riñas, al menos un apuñalamien... 2020-11-15 09:29:39 |
 |

|
Mundo.-
Trump acepta que Biden ganó elección de Estados Unidos; "fue amañada" |
| El presidente de Estados Unidos acusó una serie de irregularidades en la elección aunque aceptó que Biden se alzó con la victoria
2020-11-15 09:27:22 |
 |

|
Nacional.-
El outsourcing es lo peor que le pasó a los trabajadores. Que se regule a las empresas: sindicatos |
| La iniciativa para regular el outsourcing generó un debate entre empresarios, quienes la rechazan y la ven inviable, y los especialistas en materia laboral ... 2020-11-15 09:25:03 |
 |

|
En boca de todos.-
¿Qué es Sí por México? ¿Un simple bloque opositor? ¿Movimiento de una élite que perdió privilegios? |
| Sí por México merece el beneficio de la duda. Es un movimiento ciudadano que aunque no está libre de intereses de grupo, sí representa una oportunidad para ... 2020-11-15 09:22:28 |
 |

|
Mundo.-
Científicos de EU cazan nido de avispas gigantes. En Japón matan
y se comen. Acá, acaban con abejas |
| Las avistas asesinas tienen un gusto especial por las abejas. Acaban con nidos completos. Son un peligro para la producción de miel (México es un alto produ... 2020-11-15 09:20:52 |
 |

|
Mundo.-
La eficacia de nuestra vacuna podría variar hacia arriba o hacia abajo; el análisis sigue: Pfizer España |
| La compañía farmacéutica, encargada de anunciar los optimistas resultados sobre la vacuna contra la COVID-19 esta semana, ha atendido a AS para dar más deta... 2020-11-15 09:19:30 |
 |

